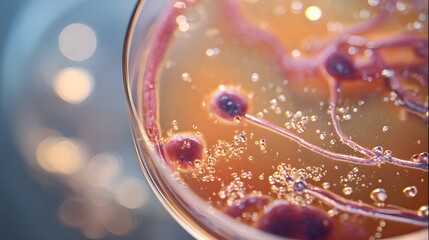
Close up of cells in a petri dish with liquid and bubbles for scientific research and study of life

- Home >
- Stock Photos >
- Virus Cells and DNA on Abstract Background
Virus Cells and DNA on Abstract Background Image

Illustrates virus cells with a DNA helix in the background, highlighting themes of health and medicine. Suitable for educational materials, scientific presentations, or articles related to COVID-19 and virology. The abstract background can be useful for graphics and animations exploring cellular biology or epidemic studies.
2
downloads
downloads
Tags:
More
Credit Photo
If you would like to credit the Photo, here are some ways you can do so
Text Link
photo Link
<span class="text-link">
<span>
<a target="_blank" href=https://pikwizard.com/photo/virus-cells-and-dna-on-abstract-background/750e0116fe125590106b5516491440e9/>PikWizard</a>
</span>
</span>
<span class="image-link">
<span
style="margin: 0 0 20px 0; display: inline-block; vertical-align: middle; width: 100%;"
>
<a
target="_blank"
href="https://pikwizard.com/photo/virus-cells-and-dna-on-abstract-background/750e0116fe125590106b5516491440e9/"
style="text-decoration: none; font-size: 10px; margin: 0;"
>
<img src="https://pikwizard.com/pw/medium/750e0116fe125590106b5516491440e9.jpg" style="margin: 0; width: 100%;" alt="" />
<p style="font-size: 12px; margin: 0;">PikWizard</p>
</a>
</span>
</span>
Free (free of charge)
Free for personal and commercial use.
Author: Creative Art
Similar Free Stock Images
Loading...